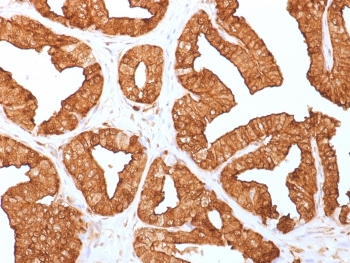
Annexin A1 Antibody
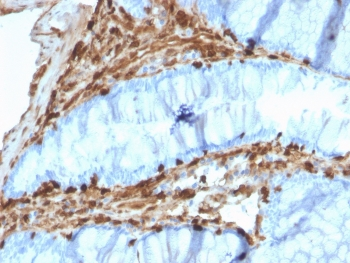
Annexin A1 Antibody

You have no items in your shopping cart.
Search results for: 'ANXA1'
- Annexin I rabbit pAb [orb768587]Featured

ELISA, WB
Human, Mouse, Rat
Polyclonal
Unconjugated
50 μl, 100 μl - Annexin A1 Antibody [orb1246601]
ELISA, WB
Human, Mouse, Porcine, Rat
Bovine, Canine
Polyclonal
Unconjugated
0.1 mg - ANXA1 Antibody, KO Validated [orb1274548]Featured

IF, IHC, WB
Human, Mouse
Polyclonal
Unconjugated
100 μl - Human Annexin A1 (ANXA1) EasyStep ELISA Kit [orb1950121]Featured

Human
0.32-20 ng/mL
16.8 pg/mL
96 T, 48 T - Human ANXA1 [orb2995233]
Unconjugated
SDS-PAGE: Greater than 95% as determined by reducing SDS-PAGE.
Predicted: 38.58 KDa. Observed: 34 KDa, reducing conditions
1 mg, 500 μg, 50 μg, 10 μg